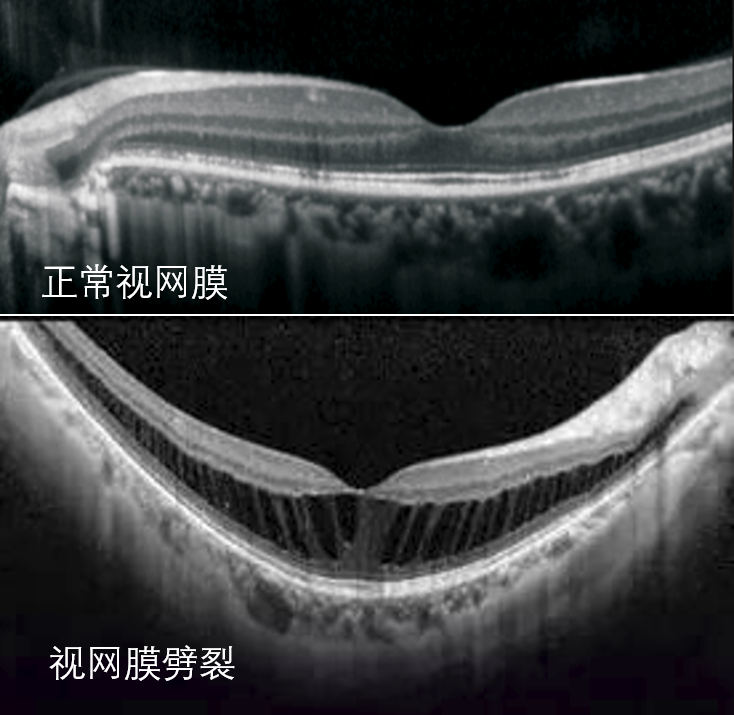
视网膜劈裂:视网膜脱离是眼球里面的水,通过视网膜裂孔流入视网膜下

视网膜劈裂症

视网膜劈裂:视网膜脱离是眼球里面的水,通过视网膜裂孔流入视网膜下
图片尺寸734x715
视网膜劈裂精彩图片
图片尺寸768x576
隆起呈纱幕样改变先天性视网膜劈裂,又称为x连锁青少年型视网膜劈裂症
图片尺寸667x278
视网膜劈裂精彩图片
图片尺寸768x576
先天性视网膜劈裂症
图片尺寸364x323
案例分享基因检测辅助诊断眼科遗传病视网膜劈裂症
图片尺寸396x363
nejm:x性连锁遗传性视网膜劈裂症-病例报道
图片尺寸588x454
原因不明的双眼视网膜劈裂症一例
图片尺寸3346x654
视网膜震荡
图片尺寸1080x810
每周最佳病例分享 | 青光眼合并视网膜劈裂
图片尺寸639x426
由于视网膜萎缩变性或玻璃体牵引形成视网膜裂孔,玻璃体对孔缘牵引
图片尺寸1080x805
案例分析先天性视网膜劈裂
图片尺寸1024x759
高度近视黄斑劈裂_近视_疾病介绍_病因_症状_遗传_手术_治疗方法_介绍
图片尺寸960x720
视网膜劈裂查因-丁小燕组
图片尺寸4032x3024
高血糖对血管的不断损害,观察到视网膜血管出现微血管瘤时为糖网i期
图片尺寸597x408
视网膜裂孔
图片尺寸900x636
视网膜劈裂
图片尺寸1080x824
近视性黄斑区视网膜劈裂的临床特征及危险因素分析
图片尺寸700x323
视力检查,裂隙,球体,特写,虹膜,眼_高清图片_全景视觉
图片尺寸670x670
什么是遗传性视网膜劈裂症 - 好大夫在线
图片尺寸2336x4160